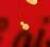

avisa Jule
Ringebu • Sør Fron • Nord Fron • Sel • Vågå
Dette blir mer og mer populært

Mange har oppdaget gleden av å benytte seg av gjenbruk. Julehandelen i gjenbruksbutikker er intet unntak. Flere og flere besøker bruktbutikker i forbindelse med julehandelen.
– Det er artig å se at folk benytter seg av slike butikker også i forbindelse med jula, sier Pål Kristian Moen.
Han jobber med butikken Handelsbua Otta og har merket en stor økning av kunder siden butikken åpnet.
– Det er gledelig å se at flere og flere finner oss, sier Moen. Handelsbua Otta er tilknyttet

Giax attføring og åpnet for en tid tilbake i nyoppussede lokaler i Øya-området på Otta.
Omfattende
Det kan godt skrives at et besøk i gjenbruksbutikker kan sammenlignes med å gå på skattejakt. Pål Kristian Moen forteller at de får inn veldig mye varer de kan by fram. Faktisk så mye at de ikke har plass til alt i butikken samtidig.
– Folk er flinke til å levere varer til gjenbruk. Noen kommer med enkeltgjenstander. Andre igjen flytter fra eneboliger til leiligheter og har ikke behov for så mange gjenstander som tidligere. Vi har også en ordning med at vi kan reise ut og hente gjenstander til folk som ikke kan frakte selv, sier Moen.
Eget verksted
Giax attføring disponerer eget verksted vegg i vegg med butikken. Det betyr at de kan reparere møbler om de har fått en liten skade. Dessuten produserer de produkter selv for salg. En rundtur i

butikken forteller om et veldig variert vareutvalg.
– Her har vi varer som er levert av folk som ikke har bruk for dem mer, men dette er varer som kan bli en skatt for andre, sier Moen. Han forteller at butikken tar imot de fleste typer varer til gjenbruk, med unntak av klær til voksne, madrasser og bøker.
Julegaver
Bente Bye Flyen ved Ting og Tøy på Otta forteller at julehandelen der i gården er godt i gang.
– Mange handler inn noe de selv har bruk for, men det selges også mange gjenstander som julegaver her i butikken, sier Flyen.
Hun forteller at butikken får mange fine gjenstander, de fleste av dem framstår som nye der de står i hyllene.
– Gjenbruk til julehandelen er absolutt populært, sier Flyen.

Bente Bye Flyen, Tove Wahl Stampen og Margrethe Lindsøe ved Ting og Tøy på Otta forteller at gjenbruk også er populært i julehandelen.
Da Handelsbua Otta fikk inn ei dør som ikke kunne brukes til det den var ment for, laget verkstedet til Giax like godt et skap.
Pål Kristian Moen i Handelsbua Otta forteller at gjenbruk er populært også i julehandelen.
I butikken er det også hyller og andre gjenstander som er produsert av Giax attføring.
Velkommen
til trivelig julehandel
med et stort utvalg butikker, hyggelige spisesteder og lange åpningstider




Søndagsåpent (14/12): 14:00-18:00
Søndagsåpent (21/12): 14:00-18:00




Lille julaften (23/12): 10:00-18:00 Julaften (24/12): 10:00 - 13:00


















3 DAGER MED
Bokhandel – Leker – Klær & sko – Møbler & interiør Normal – Vinmonopol – Apotek – Dagligvare – Frisør. Alt du trenger til jul finner du på ett sted, midt i Otta Sentrum
• 2 spisesteder • 20 butikker
tar over Gålå-kaféen Sans-innehaverne
Vi har hatt lyst til å utvide driften. Nå dukket de perfekte lokalene opp, sier driverne av Sans Kafé på Vinstra.
Grethe Ruud og dattera Helene Ruud Nordlien skal nå drive kafé både i Lomoen på Vinstra og på Gålå.
– Gjestene våre på Vinstra, skal kjenne seg igjen også når de kommer til fjells, sier Grethe, som er ei av tre damer som startet opp Sans Kafé for fire år siden. Etter at de to andre trakk seg ut, har Grethe fortsatt driften sammen med dattera Helene. I starten gikk det litt tungt. Mor og datter var litt slitne – og i januar 2023 vurderte de å selge.
– Så snudde det. Sommersesongen i fjor hadde vi 50 prosent omsetningsøkning, forteller Grethe, og legger til at det var stas og gav ekstra motivasjon og energi å bli nominert til Verdiskapningsprisen 2024, av Gudbrandsdal Næringsforening.
Utvider
Grethe og Helene forteller at de i et års tid har hatt lyst på å utvide driften. De har vært på utkikk etter nye lokaler.
– Da muligheten for å drive fjellkaféen ved alpinanlegget på Gålå kom, måtte vi bare slå til, smiler en fornøyd Grethe. Sans-kaféen har gjennom disse fire åra fått et godt ord på seg, hva så vel mat, interiør og vertskap angår.
– Vi fokuserer på å levere et godt produkt. Vi baker sjøl, og maten er laget fra bunnen av, med lokalt dølakjøtt. Den er ikke masseprodusert. Vi kjører det samme konseptet på begge kaféene, men muligens en litt annen meny på fjellet. Det som er gjevt nede i bygda, er ikke nødvendigvis like populært på en fjellkafé. Etter å ha vært ute på ski, ønsker en seg gjerne noe varmt i kroppen. Vi må prøve oss fram, for eksempel med rømmegrøt og supper.
Kvalitet
Brita Knutsen Dahl i Gålå Muligheter AS og Aktiv AS, er svært godt fornøyd med å ha fått på plass Sans-duoen på kaféen ved skianlegget.
– De har soliditet, kvalitet og sterke verdier som passer svært godt på kaféen på Gålå. De tilfører både kvalitet og personlighet. At de ønsker å være med på GålåLøftet betyr mye for oss, gjester og for hele destinasjonen, sier Brita Knutsen Dahl, som opprinnelig er fra Stord. Hun startet karrieren sin innen reiselivet på Gålå i 1990. 13 år senere havnet hun på Svalbard, som daglig leder for Basecamp Spitsbergen. Tidligere i år ble hun tildelt

Kongens Fortjenstmedalje for over 30 års innsats for norsk reiseliv. Nå er 59-åringen tilbake i Gudbrandsdalen, og er glad for at Gålå er i ferd med å styrke seg som helårsdestinasjon. Stolheisen til Valsfjell har vært stengt siden 2021. Nå er en ny T-krokheis på plass, med forventet åpning før jul.
20. desember
– Med ny heis og et levende arrangementstilbud, er Gålå inne i ei spennende utviklingsfase. At

Vi gleder oss til å starte opp på Gålå, sier Grethe Ruud og Helene Ruud Nordlien.
Sans Kafé er med på dette, er flott. Vi satser på at kaféen blir et naturlig samlingspunkt for skigjester, hyttefolk, sommergjester og lokalbefolkningen. Sammen skal vi styrke Gålå som helårsdestinasjon, sier Brita Dahl Knutsen.
– Vi satser på å åpne fjellkaféen – som sjølsagt får navnet «Sans for Gålå» - 20. desember, samme dag som den nye heisen starter opp, avslutter Grethe Ruud og Helene Ruud Nordlien. TEKST OG FOTO: GEIR TEIGØYEN

Grethe Ruud og Helene Ruud Nordlien satser gjenbruksmøbler, både på kaféen i Lomoen og på «Sans for Gålå».
Grethe Ruud (f.v.), Helene Ruud Nordlien og Brita Knutsen Dahl da de signerte leieavtalen tidligere i høst.
Kulturfestivalen 2026
Gi en gave som røsker
Legg opplevelser under juletreet, med forestillinger, konserter og middager i vakre omgivelser på Gålå og i Gudbrandsdalen.
Bestill billetter på peergynt.no


Jul på



FREDAG 05. DESEMBER LUKKET LAG, FRA KL. 19:00 Åpen kafè fram til 18:00, kun for inviterte utover kvelden.
LØRDAG 06. DESEMBER JULEBORD MED STOR JULEBUFFET
Bli med oss på en hyggelig julebordskveld! Vi byr på stor buffet med julens smaker, selvsagt både varmt, kaldt og dessert. Pris: 465,-. Kun forhåndsreservasjon. Ledig plass!
SØNDAG 07. DESEMBER FAMILIEJULEBORD
Ta med storfamilien ut på en koselig førjulsmiddag. Vi byr på stor buffet med julens smaker, selvsagt både varmt, kaldt og dessert. Anbefaler bordreservasjon denne dagen!
FREDAG 12. DESEMBER QUIZ, RUNDE 7 OG SESONGAVSLUTNING FRA KL. 20:00 Pizzabuffet fra kl. 19:30. Maks 4 pr. lag. Åpent til 24:00
FREDAG 19. DESEMBER SPILLKVELD - FRA KL. 19:00
Bli med på en uhøytidelig og sosial kveld! Lån spill av oss, eller ta med deg det du ønsker. Åpent til 23:00.
LØRDAG 20. DESEMBER MUSIKKBINGO - FRA KL. 21:00
Kombinasjon av bingo og musikkquiz. Delta alene eller sammen med vennegjengen! Åpent til 02:00
TIRSDAG 23. DESEMBER KAFÈEN ER ÅPEN 11- 17 (kjøkken 11-17)



Vi ønsker alle en fin adventstid og en riktig god jul!


TORSDAG 25. DESEMBER STENGT
FREDAG 26. DESEMBER 2. DAG JUL på Pillarguri

I år kjører vi på med karaokekveld!

ONSDAG 24. DESEMBER VI HOLDER STENGT - ÅPENT FOR PÅMELDTE TIL JULAFTEN PÅ PILLARGURI - Se facebook for informasjon!
Vi åpner dørene 18:00, med mulighet for å kjøpe pizza før fest! Vi holder selvsagt åpent til 02:00. GRATIS inngang / 20års grense fra 21:00. Husk leg.plikt!
LØRDAG 27. DESEMBER JULENØTTER - fra kl. 20:00
Kafèen åpen fra 11:00 (kjøkken 11-18:30)
Pizzabuffet fra kl. 19:30. Maks 4 pr. lag. Åpent til 24:00
SØNDAG 28. DESEMBER KAFÉEN ER ÅPEN FRA 13-20. (KJØKKEN 13-19)
FAMILIEQUIZ - fra kl. 17:00
Velkommen på en morsom Familiequiz for barn i alle aldre! Pizzabuffet fra kl. 16:30 og quizstart 17:00! Ingen påmeldingsavgift - ingen begrensninger på lagstørrelse
MANDAG 29. DESEMBER KAFÉEN ER ÅPEN 11-19 (kjøkken 11-18)
TIRSAG 30. DESEMBER KAFÉEN ER ÅPEN 11-19 (kjøkken 11-18)

ONSDAG 31. DESEMBER STENGT


Åpner interiørbutikk med kafé i Ringebu
Danielle og Nandi Ribbink
åpner snart butikken
Koselig tid, som skal være en interiørbutikk med kafé.
I Gudbrandsdalsvegen 2050 i Ringebu, vis-a-vis Tanken-bensinstasjonen, er ekteparet Danielle og Nandi Ribbink i full gang med maling, snekring og annen oppussing. Etter hvert skal
rørleggere og elektrikere gjøre jobben sin, i det 150 kvadratmeter store lokalet.
– Og så må vi ha godkjenning av Mattilsynet, sier ekteparet Ribbink, som er bosatt i Fåvang.
Erfaring med butikkdrift har de fra før. Allerede som 18-åring startet Danielle sin første butikk sammen med Nandi – med klær og utstyr til babyer. På nyåret en gang skal de åpne interiørbutikk, der de også vil tilby kaffe fra Tingnes, et lite familiedrevet kaffebrenneri midt i Mjøsa på Tingnes i Innlandet. Hjemmelagede kaker og diverse lunsjretter står også på menyen.
I bedriften Norges Drøm i Fåvang har ekteparet de fire siste åra har produsert figurlys, duftlys og duftvoks. Nå skal disse produktene selges i den nye butikken.
– Vi skal selge masse forskjellig. Ikke store ting, som bord for eksempel. Vi satser på små ting, litt dekorasjonspynt, juleutstyr og lys. Og så blir det litt til kjøkkenet og badet også. Begge jobber deltid, så de planlegger å ha åpent onsdag til fredag, fra klokka til 18, samt lørdager fra til 15.
TEKST OG FOTO: GEIR TEIGØYEN
Vi håper å kunne tilby god stemning i Ringebu med den nye butikken, sier Nandi og Danielle Ribbink.











































Vi er klare for en desember med



Julegavene finner dere hos oss på Skoringen
ALTI OTTA
Korpberget Bilpleie: Gir kjøretøy et nytt liv
Emil Wadahl Korpberget er banemontørlærling og bilpleier. – Det går mye i jobbing for tida. Men jeg stortrives både ved jernbanen og med å pusse på biler, smiler Emil Wadahl Korpberget.
– Jeg jobber ei uke på jernbanen og har ei uke av. Friuka bruker jeg til å shine biler, motorsykler, ATV-er og traktorer for folk. Jeg har til og med lagt lakkbeskyttelse på ei hyttedør og en garasjeport på Gålå.
Til våren skal 22-åringen opp til fagprøve og håper å få fortsette i Baneservice.
– Jeg får gode tilbakemeldinger og håper å få fast jobb. Det er fint med en slik turnusrotasjon. Da får jeg anledning til å gnukke og gni på ulike kjøretøyer i friuka.
Fra hobby til jobb
Også når det gjelder bilpleie, får Emil gode tilbakemeldinger. Han startet så smått opp, på hobbybasis, hjemme i garasjen hos faren sin i 2020, før han fikk disponere besteforeldrenes dobbeltgarasje i Brudalen på Harpefoss. I vår ble pågangen så stor, at han opprettet eget enkeltpersonforetak. I oktober etablerte han virksomheten i Rolstad-bygget i Maskinveien 1 på Vinstra.

Forskjellige børster og diverse Angelwaxprodukter må

– Det er ypperlig, for det kan ikke være for rått og kaldt der jeg driver. Gradestokken bør vise over ti grader. Coating trenger denne temperaturen for å herde igjennom, forklarer Emil, som har kurset seg i faget hos Lill-Wax på Lillehammer.
– Etter det første kurset, fikk jeg prøve meg på bilen til broder’n, og etter hvert har det tatt av. Nå har jeg lange ventelister, så det blir ofte arbeidsdager på tolv timer i «friukene» mine.
Tre trinn
Det er flest personbilkunder som tar kontakt med Emil, for å få reparert steinsprutskader og riper, renset, polert og beskyttet lakken med keramisk coating. Han utfører også grundig våtrens av stoffseter i bilene. Kundene bestemmer sjøl hvor grundig poleringen skal være.
– Det er tre trinn, og jeg avklarer alltid med kunden i forkant hvor grundig jeg skal være. Den rimeligste løsningen koster noe få tusenlapper.
– Dette er et tålmodighetsarbeid som krever nøyaktighet?
– Jeg legger coatingen for hånd, og da er det viktig å ha godt lys og å være nøye. Coatingen skal vare i minst to år. I tillegg er det mye maskinelt arbeid, med diverse maskiner og ulike puter. En slik service tar minst to dager, kanskje tre. Coating må ha rundt 12 timers tørketid, før kjøretøyet kan tas i bruk. Etter at jeg er ferdig, bør bilen ikke vaskes på minst sju dager. Da kan behandlingen holde i to år, om en vasker bilen jevnlig. Det er forresten stor forskjell på kvaliteten i klarlakken på nye biler. De japanske bilene har mjukere og tynnere lakk enn for eksempel de tyske. Sluttproduktet av keramisk coating er ikke bare at bilen ser blank
ut, men også fjerning av for eksempel riper og asfaltflekker.
– Hvem er den typiske kunden din?
– Det er et stort sprang. Jeg har hatt en 17-åring som øvelseskjørte hit, og eldstemann foreløpig var 75 år. Mange kommer med nybrukte biler fra forhandler, med lav kilometerstand. Jeg har også vært i Tretten for å polere og legge coating på en traktor. Da blir den lettere å vaske etterpå. Hvis folk ønsker å få polert bilen sin mens de er på hytta, henter jeg bilen, polerer og legger coating, og leverer den igjen etter to-tre dager.
– Er du nøye med din egen bil, da?
– Vanligvis håndvasker jeg bilen hver uke. Jeg har aldri vasket min egen bil med børster i bilvaskemaskin, og det kommer heller ikke til å skje. Noen sier jeg er litt for nøye, men jeg liker å ha bil, hus og hjem på stell. Foreløpig bor jeg hos far min, så han nyter godt av at jeg liker å ha det rent, smiler Emil, som ikke har noen drøm om å bli bilpleier på heltid.
– Jeg stortrives slik jeg har det nå. Jeg opplever et fantastisk arbeidsmiljø i Baneservice. I bilpleiefirmaet arbeider jeg mest alene, men det blir ikke ensomt. Jeg har mange trivelig samtaler med kundene. Drømmen er kanskje å ansette en person, men denne må ha genuin interesse for bil, i tillegg til å være nøye og tålmodig.
Mange polerer bilen sin sjøl, og Emil forteller at mange ikke alltid treffer med valg av poleringsmiddel.
– Noen poleringsmiddel inneholder mye olje, som bare fyller ripene. Det gjør at lakken ser veldig bra ut, men etter første vask, er effekten borte, avslutter Emil Wadahl Korpberget. TEKST OG FOTO: GEIR TEIGØYEN
Emil Wadahl Korpberget polerer denne Range Roveren, som en kunde nettopp hadde kjøpt brukt.
til for å få et godt resultat.




Velkommen til RINGEBU OPTIKK i Ringebu

Ringebu Optikk har egen import og eksklusivt salg av solbriller og innfatninger, produsert i Frankrike, Spania, Tyskland, Italia og Japan.




Jeg har 45 års erfaring som optiker med egen forretning. Første driftsår var 29. november 1979.
Det er veldig viktig for meg å ha fornøyde kunder med tøffe og komfortable briller som ikke finnes ellers i markedet, og som er godt








tilpasset hver enkelt kunde. Ringebu Optikk har et bredt spekter av kvalitetsprodukter innen briller, solbriller og kontaktlinser og står for kvalitet og gammeldags god service.
Velkommen til Ringebu Optikk i Ringebu!
VI FØRER DISSE MERKENE: fra Spania fra Italia fra Tyskland






Du finner oss i mølla, Ole Steigs gate 13 i Ringebu Tlf. 908 25 677
Åpningstider: mandag - fredag kl. 09.30 - 16.30
Til kunder som ikke har tid fra mandag til og med fredag kan vi avtale tidspunkt på lørdag.

JAPANSK TITAN KOLLEKSJONER FRA:
Foto: Marijebaan photography

I dette huset kommer julstemningen som perler på en snor. Otta kulturhus ber nemlig inn til hele fire julekonserter fra nå og høytiden setter inn.
Fra den 5. desember til 15. desember kan du neppe unngå å få julestemning fra scenen i kulturhuset. I løpet av fire forskjellige konserter leverer Emil Solli-Tangen, Otta musikkforening med gjester, Tenorane og Steffen Horn og Alexandra Rotan med gjester julekonserter i kulturhuset.
– Julekonserter er veldig populært, sier Kaare Bryhn. Høydepunkt
Men det er ikke kun førjula som markeres i det store kulturbygget ved Otta sentrum.
Gjennom år har Kaare Bryhn bydd på det ene høydepunktet etter det andre fra scenen til Otta kulturhus. Og programmet framover viser at kulturglade innbyggere i Gudbrandsdalen kan glede seg også til framtida. Vi kan jo ikke nevne alle som allerede står på plakaten framover, men Espen Lind, Jon Brungot, Terje Sporsem, en hyllest til Håkon Banken er noe av det som står på plakatene i starten av neste år.
Stort omland
Det er nemlig ikke slik at det er kun folk fra Sel og nabokommuner som kommer på besøk når dørene åpnes til en eller annen kulturbegivenhet, enten det dreier seg om musikk, teater eller andre kulturelle innslag.
– Otta kulturhus er et hus til glede for hele regionen. Vi har besøkende fra hele dalen, og det
kommer publikum også fra andre steder i landet når vi har gode navn på plakatene, sier Bryhn.
Ildsjeler
Det var flere ildsjeler som for en del år tilbake arbeidet godt for å få et nytt kulturhus til regionsenteret. Det arbeidet ga etter hvert frukter og Otta kan sole seg i glansen av det som mange kaller et praktbygg.
– Vi skal være glade for at kulturhuset ble bygd i den tidsperioden det ble reist på. Slik situasjonen er nå, ville det nok blitt dobbelt så dyrt å bygge det nå. De som har planer om å bygge nytt kulturhus nå, vil få utfordringer, sier Kaare Bryhn.
Økning
Om vi skrur tiden en del år tilbake og ser på de kulturtilbudene som var i det gamle kulturhuset, vil vi se at omfanget, og variasjonen, innen kulturtilbudene har økt betydelig.
Situasjonen for artister og skuespillere som skal på scenen i kulturhuset har også fått en enklere arbeidsdag enn det som var tilfelle tidligere. Et godt eksempel på det, kan være at band med mye utstyr nå kan rygge rett inn gjennom en diger port og losse av utstyret like ved scenen.
– Alle som kommer hit er imponert over hvordan det er lagt til rette, sier Bryhn.


Setene i kulturhuset blir ofte besøkt av både lokale, regionale og langsveisfarende publikummere.
Veggene på kontoret til Kaare Bryhn vitner om at Otta kulturhus har presentert mange toppartister på scenen.

Maken til stemning
skal du lete lenge etter
Tenorane og Steffen Horn er en av fire grupper som skal holde julekonsert i Otta kulturhus.


Julestemning
på Peer Gynt senteret




LANGÅPENT:
Lørdag 20. desember:
Senteret fra kl. 10-18 (Kiwi 07-23)
SØNDAGSÅPENT:
Søndag 7. desember: Kiwi fra kl. 14-20
Søndag 14. og 21. desember: Senteret fra kl. 14-18 (Kiwi 14-20)
ÅPNINGSTIDER JUL:
Julaften: 10-13 (Kiwi 07-16)
Romjula: 10-16 (Kiwi 07-23)
Nyttårsaften: 10-13 (Kiwi 07-16)

DET STORE BALLONGSLIPPET!
Søndag 14. desember KL. 15
Se mer info på vår facebookside eller på peergyntsenter.no

Mandag - fredag 10.00 - 18.00
Lørdag 10.00 - 16.00 Mandag - lørdag 07.00 - 23.00 Lørdag 07.00 - 23.00
Peer Gynt Kjøpesenter Vinstragata 88 2640 Vinstra post@peergyntsenter.no www.peergyntsenter.no



Julegavetips


Sjekk vårt gode utvalg av kikkerter!





























Johan Nygårdsgate 11, 2670 Otta Tlf. 61 23 02 80 - post@optikersaastad.no
Amfi Otta -2670 Otta Tlf. 61 23 02 80 post@optikersaastad.no



OTTAKORTET kjøper du hos Mona på Skoringen, Alti Otta Mandag-fredag: 10.00–20.00 Lørdag: 10.00–18.00
For bestilling med fakturering: otta@skoringen.no Telefon 93 68 17 03
DØLER I KRIG
Boka viser krigens grusomheter, fortalt gjennom mange av dem som opplevde andre verdenskrig i kampene langs Mjøsa og gjennom Gudbrandsdalen, med vekt på Nord- og Midt-Gudbrandsdalen.



Boka selges i disse butikkene:





Les om boka på denne nettsiden.
Utgivere: Lokalhistorikerne
Kjell Arne Bakke og Morten Tullut
• Norli Otta, Vinstra og Ringebu • Hageland Bjørke, Kvam • Joker Sel
• Sjoa Mat og Bensin • Extra Dombås • Coop Prix, Dovre • Joker Lesja
• Vågå Bok og Leker • Rustugusetra • Høvringen Landhandleri og Kafé
• Mysuseter Servicesenter • Anton & James Bokhandel, Storgata 40, Lillehammer • Norli Storgata 61, Lillehammer
Boka selges også her:
/ www.krigsopplevelser.no
Kjell Arne Bakke og Morten Tullut

Reidun Løkken Kongsli: Mater familias og ja-menneske
Reidun Løkken Kongsli koser seg når hun baker lefse. Foto: Geir Teigøyen

– Dess mer du gir, dess mer får du tilbake, smiler Reidun Løkken Kongsli, som i sitt 86. år er «still going strong».
– Jeg føler meg ikke så gammel. Og jeg holder kanskje et litt høgt tempo sammenlignet med mange jevnaldringer. Men jeg må innrømme at det hender jeg tar meg en ettermiddagskvil, sier Reidun Løkken Kongsli, som bor på Møllerbakken på Vinstra, sammen med ektemannen Trygve. De har vært kjærester i nesten 70 år, og giftet seg i 1959.
– Vi har hatt våre feider, men hvem har ikke det, sier Reidun.
Ekteparet er svært familiekjære og kan glede seg over å være «overhoder» for fire generasjoner etter seg: fire døtre og to sønner, 14 barnebarn, tre oldebarn (pluss en til på gang) og ett tippoldebarn.
– Vi har mange snille etterkommere, som stadig kommer med kaker og mat til oss, sier 85-åringen.
Rakfisk og fettbrød I så fall, har generasjonene etter Reidun gått en god skole. Hun holder fortsatt oppe tradisjonen hun har laget, med å stikke innom butikker og diverse kontorer, for å glede de ansatte med fettbrød og annet biteti. Da undertegnede var redaktør i lokalavisa Dølen på begynnelsen av 2000-tallet, var Reidun innom i redaksjonen så å si ukentlig, med ferske bakverk. Den energiske 85-åringen er fortsatt ofte på besøk hos beboere på Sundheim Bo- og treningssenter på Vinstra.
– Jeg er på Sundheim en gang i uka eller så. Jeg har noen faste jeg besøker, blant andre Iver Myreng og Ola Lien fra Skåbu. På denne tida av året har jeg med rakfisk til karene. Det setter de stor pris på. Andre får fettbrød, og gir uttrykk for at det er det beste de vet.
Da vi var innom hos Reidun og Trygve i Rustvegen, var Reidun i full sving i kjelleren, med lefse- og flatbrødbaking.

Jeg bruker byggmjøl fra Vinstra Bruk, som sønnen vår, Asbjørn har tatt over etter Trygve, forteller ei litt stolt Reidun.
Gjestfri
At ekteparet Kongsli er sosiale og holder åpent hus, fikk vi et eksempel på da vi kom opp igjen fra kjelleren, for å drikke kaffe og smake på baksten. Der satt kvamværen Jens Tangen ved kjøkkenbordet og ventet på at husbonden skulle komme hjem. De to godt voksne karene har felles interesse for hest, og har mye å prate om.
– Jeg stikker innom hos Reidun og Trygve hver tirsdag. Det er svært trivelig, slår Jens Tangen fast.
Reidun serverte fettbrød og bløtkake under ovennevnte seanse, men hun påstår at hun nå nøyer seg med sju kakeslag til jul – og kanskje knapt det.
Jeg har trappet ned. I tidligere tider, var det helt tullete, med tolv slag, kanskje. Nå nøyer jeg meg med sandbakelse, bordstabler, sirupssnipper og et par slag til. Og så lager Trygve og jeg smultringer sammen. Han står for kokinga.
Stiller opp
Reidun har alltid vært et ja-menneske, som sprer glede, liv og røre rundt seg. Det ble hun hedret for på midten av 1990-tallet. Daværende avis G & LT og Strandtorget kjøpesenter på Lillehammer arrangerte ei morsdagskonkurranse, der leserne og kundene skulle stemme fram «Distriktets beste mor». Reidun vant denne hederstittelen. Det var yngstedatter Gunhild som nominerte mor si, og rundt 30 år senere gjentar Gunhild gjerne noe av begrunnelsen hun kom med den gangen.
– Mor mi er det mest positive mennesket som finnes. Hun er oppofrende, vennlig og stiller opp for andre. Hun sprer godt humør rundt seg, og har et stort og godt hjerte. Og så er hun svært glad i familien sin, sier Gunhild Kongsli.
Det latinske uttrykket «mater familias» passer på Reidun. Hun er virkelig familiens kvinnelige overhode og moderlige midtpunkt.
– Det gir meg mye å besøke folk og prøve å glede andre. Alltid når jeg kommer hjem, setter jeg meg ned og tenker over hvor godt jeg har det, sier Reidun Løkken Kongsli.
AV GEIR TEIGØYEN
Reidun gleder seg over å kunne bruke byggmjøl fra Vinstra Bruk.
«Distriktets beste mor» - faksimile fra G & LT.

Julekonserter:
Travelt for Vox Vaala
Desember står i julekonsertenes tegn. Medlemmene i Vox Vaala-koret skal gjennomføre tre konserter.
– Det blir travelt, men morsomt og koselig, sier lederen i Vox Vaala, Marianne Gausen Onshus om desember-programmet til Ringebu-koret, som består av 20 sangere fra Ringebu i nord til Lillehammer i sør.
Lørdag 6. desember og søndag 7. desember skal Vox Vaala delta i julekonserter på henholdsvis Rudi gard og i Otta kulturhus, sammen med Otta musikkforening, Mari Midtli og Jørgen Ryen som sangsolister og Edin Johan Høier ved pianoet.
– Vi skal framføre fem sanger med korps og solister, i tillegg til to egne sanger. Blant annet Halleluja-koret fra Händels Messias og «Deilig er jorden» står på programmet. Dette blir artig og utfordrende. Vi ser fram til å prøve noe nytt, sier Marianne Gausen Onshus.
Julesalong
I 2018 startet Vox Vaala med salong-konseptet sitt, med lune og stemningsfulle konserter i Kaupanger. Årets julesalong står på programmet på dagtid lørdag 13. desember. Da fylles gamle, ærverdige Kaupanger med julelys, juletre og en stemningsfull atmosfære.

– Julesalongen er en god tradisjon, som pleier å trekke fullt hus. Mange er ute og handler denne lørdagen, og da er julesalongen et lite avbrekk i julestria. Det er gratis inngang og salg av kaffe, sier Gausen Onshus. Hun kan lokke med et vidt spekter av julesanger – fra de gode, gamle norske sangene til mer rytmiske sanger, fra den amerikanske a capella-gruppa Pentatonix.
Vox Vaala er et allsidig blandakor, med 20 aktive medlemmer. Koret hadde sin spede begynnelse under navnet «Olsenbanden» i 1986, og ble mer seriøse og tok navnet Vox Vaala sju år senere. Navnet kommer fra latinske «vox», som betyr stemme og Vaala etter elva i landsbyen. Koret teller for tida fem mannlige sangere – tre basser og to tenorer, i tillegg til damestemmene.
– Vi har for få mannsstemmer, så flere av damene er innom tenorstemma. Jeg synger fast tenor. Det går stort sett greit, sjøl om jeg eventuelt må hoppe over et par toner innimellom, smiler lederen i koret.
Pål Svindland har vært korets dirigent siden 2019. Heidølen omtaler seg sjøl som «kulturpotet». Han underviser ved Sel kulturskole, har saksofon som hovedinstrument og opptrer ofte som frilansmusiker.
– Pål er en svært musikalsk og talentfull kar. Engasjert, dyktig og alltid med ei god historie på lur. Vi er meget takknemlige for at han tar turen frå Heidal til Ringebu hver mandag, sier Marianne Gausen Onshus.
AV GEIR TEIGØYEN
Vox Vaala-sangerne ser fram til julekonsertene. FOTO: GEIR TEIGØYEN
Velkommen til julesalong på Kaupanger og konsertene med Otta musikkkforening, sier Marianne Gausen Onshus og
Pål Svindland. FOTO: GEIR TEIGØYEN

Utvalgte julekonserter
5. des.: Musikklinja ved Vinstra vidaregåande skule – Sør-Fron kirke
5. des.: Emil Solli-Tangen – Otta kulturhus
6. des.: Helene Bøksle – Sør-Fron kirke
6. des.: Otta musikkforening, Vox Vaala med flere – Rudi gard
6. des.: Vokalgruppa Chablis og Tom Willy Rustad – Sans kafé og bar
7. des.: Otta musikkforening, Vox Vaala med flere – Otta kulturhus
7. des.: Sigrid Moldestad & Hazelius Hedin – Rudi gard
11. des.: «Desemberkveld» med Randi Marie Steig og Erik Granlien – Sør-Fron kirke
12. des.: Vinstra musikklag – Sødorp kirke
13. des.: «Julesalong» med Vox Vaala – Kaupanger, Ringebu
14. des.: Norsk Et Lite Kor – Sødorp kirke
14. des.: Ranglarkampen kamferkor og Sel kulturskole – Sel kirke
14. des.: Dovrefjell Disharmoniske Selskab og Lesja og Dovre kulturskole – Dombås kirke
15. des.: Kvam musikkforening – Kvam kirke
15. des.: Camilla Granlien og MjøsFolk – Ringebu prestegard
19. des.: «Jul med Valdresmål og meining» - Rudi gard
21. des.: «Bygdas egen julekonsert» - Sør-Fron kirke
22. des.: «Folkelig jul» med Marie Klåpbakken – Sødorp kirke


Vi syr alt til hus og hy e

♦ Stort utvalg i sto er
Green Apple
Prestigious tekstil


♦ Pagunette m.m
♦ Måltilpasset søm ♦ Lang og god erfarig
Mange gode gaveideer i butikken Velkommen innom s!
























































VÅRE MERKER:







FRANSA – KAFFE
CREAM – B-YOUNG





MARC LAUGE – BLEND
LINDBERGH – BISON
JACK´S – GIOVANI





MOVE ON – MANZINI
oss på Velkommen til en hyggelig handel!

Nedregata 1 (Sødorptunet), 2640 Vinstra • Tlf.

Julevarer har for lengst fått plass i skap og hyller i butikkene.
Adrian Johnsen er den nye driveren av Rema 1000. Hilde Aspeslåen åpnet nylig butikken Kid i kjøpesenteret på Otta.
Grugledet seg
Adrian Johnsen begynte å jobbe i butikk på Lillehammer da han var 18 år. Han har deltatt i talentprogrammet til Rema 1000 og fikk i år tilbud om å overta som kjøpmann på Otta. I høst tok han over butikken.
– Jeg grugledet meg. Jeg har jo aldri vært sjef tidligere, men jeg synes det har gått bra, sier kjøpmannen.
Han ser fram til å bli med på sin første julehandel som kjøpmann.
– Jeg elsker jul og jeg elsker julehandel, sier Johnsen.
Han forteller at han merker at julehandelen allerede er godt i gang. Tiden før jul er en viktig periode for oss som driver butikk, sier Johnsen.
Spennende
Det er ikke så veldig lenge siden Hilde Aspeslåen åpnet sin flunkende nye butikk, Kid, i senteret på Otta.
– Dette er veldig spennende. Vi gleder oss til den første julehandelen på Otta. Vi registrerer at folk begynner julehandelen tidlig, sier Aspeslåen.

Hun forteller at butikken i tiden før jul vil motta mange paller med julevarer. Aspeslåen har lang erfaring innen handel. Hun har drevet butikken Kid på Vinstra i 20 år.
– Nå gleder vi oss til julehandelen både på Vinstra og på Otta, sier Aspeslåen.
Milliarder
Organisasjonen Virke, kommer hvert år med en prognose for hvor mye befolkningen samlet sett
vil bruke på årets julehandel.
– Nordmenn vil bruke 149,4 milliarder kroner inkl. mva. på årets julehandel. Det er en økning på 5,5 prosent fra fjoråret. Hver og en av oss vil i snitt bruke rundt 26 700 kroner på julegaver, mat, drikke og andre varer i november og desember. Totalt vil det bli handlet for 73,3 milliarder i november og 76 milliarder i desember, når man medregner både butikk- og netthandel, skriver organisasjonen på sin hjemmeside.
Adrian Johnsen gleder seg til sin første julehandel på Otta.
Spente før sin første julehandel
I år er det første gang Adrian Johnsen og Hilde Aspeslåen kaster seg inn i julehandel på Otta. Begge gleder seg til det som for mange bedrifter er årets viktigste handelsperiode.


Hilde Aspeslåen åpnet nylig butikk i kjøpesenteret på Otta.
Kid har hatt butikk på Vinstra i 20 år. Nå har Hilde Aspeslåen også etablert butikk på Otta.








TA BUSSEN TIL JULEHANDELEN






























Se rutetider og kjøp billett i Entur-appen.






-Kjøp julegavene
lokalt
FJELLET: - Hyttekundene er en stor og viktig gruppe for oss. De sier de liker både vareutvalget og servicen hos oss, sier Tone Fjellstad.


Eli Røen og Tone Fjellstad har solgt klær, sko og leker til kunder fra Ringebu, Gudbrandsdalen, hytteområdene og Østerdalen i mange år. De to «er» Coop Trend i Landsbyen Ringebu.
Nå er de i ferd med å avslutte året som ligger an til å bli «meget bra»
Noe for alle Forklaringen?
– Vi fører gode og kjente merker til hele familien. Det er nok dameklær vi selger mest, men det går unna med herreklær også, vi har jo dalens beste herreavdeling!
Konseptet er et varesortiment som skal favne hele familien. Derfor fører vi i tillegg et stort utvalg klær til barn fra 0-16år, også her med anerkjente merker som Name it, Vero Moda girl, Only og Levi’s.
Skotøy for hele familien og leker har vi også.
Så mye av forklaringen på at vi klarer oss såpass bra, ligger nok i bredden, mener Eli Røen, butikksjefen.
Kunnskap og service
– Også må vi vel si at vi har god varekunnskap og kjenner vårt publikum godt etter alle disse årene. Og vi forsøker å ta av oss kundene våre på en god måte. Alle skal føle seg velkommen hos oss, både fastboende, fritidsbeboere og tilreisende, sier Eli og ser på kollegaen.
Det er for det meste Eli og Tone kundene møter i butikken, kundene setter pris på kjente fjes og hjelpen de får. Jeg setter min ære i at folk skal finne det de trenger på ett sted og slippe å reise ut av bygda sier Eli.
Handle lokalt
– Det er skapt et trivelig handelsmiljø i Landsbyen Ringebu, og mange trekker hit for å besøke de forskjellige nisjebutikkene som vi profiterer på. Her er det gratis parkering og gåavstand til alle butikker og serveringssteder.
Siste året har dessverre fire virksomheter her i sentrum stengt døra. Skal et lite sentrum overleve i bredde og i konkurransen mot kjøpesentre på større steder, må folk velge å handle lokalt. Bruk oss!
Coop-familien
Trend er en del av Coop Innlandet, og vært i Coop-familien siden Ringebu samvirkelags dager. Mange vil huske samvirkelaget i den røde bygningen i Hanstadgata. Siden har Trend fulgt med som en høyst synlig del av den utvidede Coop-familien via Coop Sør- Gudbrandsdal til dagens Coop Innlandet.
– Coop er først og fremst mat og byggevarer, men her i dalen er det også to Trend butikker. Det er en på Vinstra med kun dame -og herre
VI STORTRIVES!: Eli Røen (til venstre) og Tone Fjellstad har vært vegvisere inn i Trends store vareutvalg av klær, sko og leker i mange, mange år. Alle foto: Anne Stokke
PLASS: Her i Hanstadgata har forretningen holdt til i alle år.
klær. Vi fører ikke samme merker, og det er helt bevisst på grunn av kort avstand mellom Ringebu og Vinstra.
Mange blir positivt overrasket over at det er Coop Innlandet som eier butikken og at de kan bruke medlemskortet sitt. Det er fint å ha Coop i ryggen, vi står fritt til å velge leverandører selv, og det gjør det til en unik butikk. Vi er stolte av å levere et bra resultat.
Trend har ikke nettbutikk, men er aktive på sosiale medier. Varer sendes til kunder som ønsker det.
Butikksjefen ser ut over det store forretningslokalet, 550 kvadratmeter pluss lager. Proppfullt av varer en førjulsdag.
– Vi gleder oss til julehandelen.
Fellesskapet
De to erfarne butikkdamene deler en sekk full av minner og opplevelser. De har tatt imot tusenvis av kunder, fra fjern og nær.
– Lokale kunder er de viktigste på et lite sted som Ringebu, men vi har også god trafikk fra hyttefolket.
«
Skal et lite sentrum
overleve
i bredde og i konkurransen mot kjøpesentre på større steder, må folk velge å handle lokalt»
ELI BUTIKKSJEF TREND
Når kunder Oslo-området med sitt store utvalg av butikker likevel velger å handle hos oss, setter vi veldig stor pris på det. Det samme gjelder alle som kommer kjørende fra sør og nord i dalen og de som tar turen over fjellet fra Alvdal og Folldal.
– Det er heftig konkurranse om kundene da mellom Trend og Fru Frøken, Vålebrus andre spesialforretning for dameklær?
– Neida, Jorid (Dalberg, red, anm) og jeg lever godt side om side. Vi dekker hvert vårt marked og lever godt med det. Mangfold er bra!
AV ANNE STOKKE
Dette sier
kunder på nettet
• Fantastisk service, alltid spennende utvalg
• Hjelpsomme og blide damer
• God service, her finner jeg alltid noe
• Verdt et besøk når man er i Landsbyen Ringebu



KASSE: Det er blitt mange hyggelige møter med kunder gjennom årene. Her er det Rita som har handlet av butikksjef Eli.
ROMSLIG: Butikklokalet på hele 550 kvadratmeter bugner av varer. Trend har ikke netthandel, men sender varer på forespørsel.
SMÅTT: Trend er eneste forretning i Ringebu som tilbyr et bredt utvalg klær for barn.

VELKOMMEN TIL THON HOTEL OTTA
Julen nærmer seg og våre populære arrangementer fyller seg raskt opp.
6. desember - Juletapas: Få ledige
7. desember - Familielunsj: Få ledige
Åpen restaurant frem til jul.
Bestill bord på 61 21 08 00 eller otta@thon.com
DIN BILFORHANDLER












Gardiner
Duker
Dyner,
Utleie av
KONTAKT FOR AVTALE!
807
Tlf. 948 49 807
KONTAKT FOR AVTALE! E-post: helga.engum@gmail.com
E-post: vinstravaskeri@gmail.com
Tlf. 948 49 807
E-post: vinstravaskeri@gmail.com
E-post: helga.engum@gmail.com
E-post: vinstravaskeri@gmail.com
helga.engum@gmail.com
Åpningstider: Mandag stengt. Tirsdag - fredag 9-15 Utenom åpn. tid ta kontakt. Nedregate 58, 2640 VINSTRA
Åpningstider: Mandag og tirsdag stengt. Onsdag -fredag 9-15. Utenom åpn.tid ta kontakt.
Åpningstider: Mandag stengt. Tirsdag - fredag Utenom åpn. tid ta kontakt. Nedregate 58, 2640 VINSTRA
Åpningstider: Mandag stengt. Tirsdag - fredag 9-15 Utenom åpn. tid ta kontakt. Nedregate 58, 2640 VINSTRA
Åpningstider: Mandag stengt. Tirsdag - fredag 9-15 Utenom åpn. tid ta kontakt. Nedregate 58, 2640 VINSTRA
Åpningstider: Mandag stengt. Tirsdag - fredag Utenom åpn. tid ta kontakt. Nedregate 58, 2640 VINSTRA
Åpningstider: Mandag stengt. Tirsdag - fredag 9-15 Utenom åpn. tid ta kontakt. Nedregate 58, 2640
Ringebu
Sør Fron
Nord Fron
Sel
Vågå


Julegåvetips:

Vakre treprodukt frå Søre Lia
Er du på leit etter ei spesiell julegåve, kan det vere ein god ide
å ta turen til Melvin Brånå i Sør-Fron.
Då Melvin Brånå pensjonerte seg i 2012, kunne han sjå attende på 38 år innan skuleverket, som lærar, rektor og skuleleiar. Han er heidøl, men gjorde sør-frøning av seg i 1984. Han og sambuar Else Kari har bygd opp eit vakkert tun med mange bygningar på Nigard Bue i Søre Lia i Sør-Fron. Pensjonisten bruker mykje av tida si ved dreiebenken i snikkarbua der.
– Eg hadde ein dugeleg flink sløydlærar på ungdomsskulen i Heidal, Anders Johnsgard. Han inspirerte meg til å få interesse for trearbeid, og det har følgd meg sidan da. Eg har mellom anna satt opp mykje av huset her på Nigard Bue og hytta vår på Kvamfjellet, fortel, Melvin,
som kjøpte sin fyrste dreiebenk for om lag 45 år sidan.
Dei siste 10-12 åra har det gått mykje i tredreiing. Han lagar alt frå juletrekuler og vinstopparar til lysestakar og større ting som bollar, vasar og fat. Ein del av produkta er i sine naturlege farger, og mange av tinga er fargesett, med beis og olje som overflatebehandling.
– Mange av dei finaste lauvtrea veks i Mellom- og Sør-Amerika, og eg importerer mykje frå USA. I haust oppdaga eg at ein kar i Nannestad hadde ein del av desse fine treslaga. Så då tok eg turen dit og bunkra opp lageret, seier Melvin, som opp
gjennom åra har delteke på salsmesser, mellom anna i Ringebu, Venabygd og i Oslo.
– Det er løyle å lage noko som folk har lyst til å kjøpe. Eg har vore med på julemessa i Liene her i Sør-Fron sidan starten, og det er den einaste julemessa eg stiller ut produkta mine på i år. Eg tømde lageret under «Ope helg»-arrangementet i Heidal i sommar, så eg turte ikkje melde meg på fleire messer. I den grad eg har hatt produkt etter den messa, er det mogleg å ta kontakt med meg direkte, viss ein ønskjer til dømes ei julegåve i tre, avsluttar Melvin Brånå.
TEKST OG FOTO: GEIR TEIGØYEN
Melvin Brånå produserer mellom anna juletrepynt, lysestakar, bollar og fat.
Melvin Brånå trivst godt ved dreiebenken i snikkarbua.






























































Julevasken går lett med godt utstyr




















NYHET

Vi har gavene du ønsker å gi, og vi har gavene du ønsker å få




















KLIKK OG HENT PÅ JERNIA.NO
Vi pakker og ordner gavene




















KARCHER VINDUSVASKER


VINDUSNAL 29CM

FEIESETT MED LANGT SKAFT



3-PLY PREMIUM HYBRID PANNE- OG KJELESETT med høy kvalitet og har et giftfritt belegg som varer lenge.






Julebaksten




KRYSTALL SODA 450G


BØTTE 10 L MØRKEGRÅ


PÅ STELL-PRODUKTER
FIRMAGAVER
Vi hjelper deg med den perfekte julegaven til dine ansatte. Vi pakker og klargjør dine gaver. Vet du ikke hva du skal gi? Vi har Jernia gavekort.











“NY” BUTIKK Vi har gjort store forandringer i våre lokaler og ønsker alle velkommen til trivelig julehandel i ny og spennende butikk!














Følg oss på Instagram, gå inn på jerniaotta!






Tone Jakobsen: Kreativ og allsidig

Postkasser, dørskilt, nøkkelringer, vaffelgafler og barnestoler er noen eksempler på produkter Tone Jakobsen lager.
I yngre år arbeidet Tone Jakobsen innen eldreomsorgen og det som tidligere het HVPU. Så slo ryggen seg vrang, og hun måtte finne seg noe annet å gjøre. I rundt 40 år har hun syslet med maling og snekring.
– Vennene mine kaller meg malerinne, smiler Tone, og legger til at hun har fått tilbakemeldinger fra medelever på barneskolen, som husker henne som kreativ.
– Allerede da likte jeg å tegne og male, og som 20-åring begynte jeg for alvor å male.
Autodidakt
I hjemmet i Kvikne, som hun deler med ektemannen Bjørn og fem hunder, har hun ei snekkerbod i kjelleren. Der snekrer hun blant annet postkasser, barskap, barnestoler og tennbrikett-kasser. Både hjemme og på Hemlågå-butikken på Sødorptunet på Vinstra, maler hun på disse og andre produkter, som for eksempel dørskilt, mjølkespann, vaffelgafler, nøkkelringer eller premiefat. Hun driver
også med nålfilting på blant annet votter og sitteunderlag.
– Har du noen utdanning innen maling eller snekring?
– Nei, ikke ett eneste kurs. Så jeg er en autodidakt – har utviklet ferdigheter gjennom øving, prøving og feiling på egenhånd, smiler Tone, og legger til at hun nå har lyst til å begynne å dreie.
– Når andre ønsker seg for eksempel en ny sofa, vil jeg gjerne ha ei ny kappsag. På ønskelista nå, står dreiebenk.
Motivene Tone maler er ofte fri fantasi. Men kunder kommer ofte med fotografi, med ønsker om at hun skal male motivet på for eksempel ei postkasse eller et dørskilt.
– Jeg driver ikke masseproduksjon, så om en kunde ønsker seg et spesielt motiv, kan jeg som regel ikke levere på dagen.
«Bælflink»
Tone får ofte positive tilbakemeldinger fra fornøyde kunder. En av disse er Stian Staysman Thorbjørnsen, som har hytte på Gålå. Tone har laget en damefigur til artisten, som østfoldingen har presentert på facebook-profilen sin.
– Tone er bælflink, sier Staysman, på ekte østfold-dialekt.
For cirka 15 år siden, startet Tone og flere andre Hemlågå-butikken på Vinstra. De seks-sju siste åra har butikken holdt hus på Sødorptunet. Nå er Tone den eneste som driver butikken, som er ei ideell forening som drives på frivillig basis. Håndverks- og håndarbeidsprodusenter betaler 150 kroner i måneden, for å få selge produktene sine på butikken. Dette bidrar til husleia.
– Siden påske har jeg vært alene om å drive butikken, men jeg har fått med meg noen flinke, kreative damer som lager mye fint og hjelper meg i butikken. I tillegg har jeg hjelp av ei dame fra Afghanistan, som har språktrening i butikken en dag i uka, sier Tone Jakobsen.
Tone Jakobsen er i gang med å male et seterbilde.
Tone leverer håndmalte nøkkelringer med ønsket motiv.
Tones postkasser er populære.
Sødorptunet: Feiret 20-årsjubileum med økt omsetning



– Koselig å spandere frokost og marsipankake på kundene, sier Hanne Britt Jacobsen, senterleder på Sødorptunet på Vinstra.
Det var folksomt på Sødorptunet lørdag 22. november, da Sødorptunet markerte 20-årsjubileum, slik det framstår nå, som ett bygg. Det var Vinstra Samvirkelag som startet å bygge på tomta sør i Vinstra. I 1977 åpnet Domus varehus der.
– Vi har mange hyggelige og unike butikker under ett tak. Totalt 22 leietakere og 13 butikker. Vi har størst utvalg av klær og sko på Vinstra, og kan glede oss over økt omsetning i år, forteller Hanne Britt Jakobsen.
Maskoter fra Fron Sportsklubb delte ut Twist, og senterlederen bød på kaffe og marsipankake.
– Jeg bestilte kake til 60 personer, og dette gikk unna på et blunk. Kakestykkene var ikke så veldig store, så atskillig flere enn 60 fikk en smak, sier Jakobsen.
– Liv Rykhus, Ingrid Wahlquist og Liv Maurstad er faste kunder, og de var litt bekymret for å virke glupske og frampå, da de var de første til å få marsipankake.
– Vi er faste kunder og drikker kaffe her hver lørdag, presiserer de tre Vinstra-damene.
Lørdag 6. desember markerer Sødorptunet også 20-årsjubileet. Da skal Norsk Et Lite Kor stå for underholdningen.
TEKST OG FOTO: GEIR TEIGØYEN
Senterleder Hanne Britt Jakobsen serverer kaffe og marsipankake til Liv Rykhus, Ingrid Wahlquist og Liv Maurstad.
Barhaug Sanitetsforening solgte lodd. På bildet ser vi Marie Underdalshaugen (f.v.), Solveig Fagervold og Gunnveig Waagø Jacobsen.
Maskoter fra Fron Sportsklubb bød på Twist.
av energien som tilføres et bygg.
GK leverer både små og store rørtekniske installasjoner innen sanitær, varme, sprinkler, kjøl og gass. Vi utfører oppdrag for både privat- og proffkunder, og vårt fokus er å levere rasjonelle og energieffektive løsninger på alle typer bygg – enten det er næringsbygg, offentlige bygg, industri eller privatboliger.

Din lokale rørlegger
Vi er allsidig, tilgjengelig og best på service!
Kontakt GK i Vågå, tlf: 61 23 94 40 eller GK i Otta, tlf: 61 21 09 80
I dagens samfunn er energi en dyrebar ressurs og effektive rørtekniske anlegg er avgjørende for å utnytte mest mulig av energien som tilføres et bygg.
I dagens samfunn er energi en dyrebar ressurs og effektive rørtekniske anlegg er avgjørende for å utnytte mest mulig
GK leverer både små og store rørtekniske installasjoner innen sanitær, varme, sprinkler, kjøl og gass. Vi utfører oppdrag for både privat- og proffkunder, og vårt fokus er å levere rasjonelle og energieffektive løsninger på alle typer bygg – enten det er næringsbygg, offentlige bygg, industri eller privatboliger.
Vi er allsidig, tilgjengelig og best på service!
Kontakt GK i Vågå, tlf: 61 23 94 40 eller GK i Otta, tlf: 61 21 09 80















Har flyttet mange tusen varer
De har hatt noen hektiske uker og dager. Like før selve julerushet startet, har de flyttet hele varebeholdningen til nye lokaler.
Fredag åpnet de i nye lokaler. Der får kundene oppleve butikken i ny drakt. Den 11. desember inviterer Jysk på Otta til en stor åpningsfest.
Hektisk
Jysk på Otta har holdt hus i andre etasje i kjøpesenteret Alti siden 2008. Det har lenge vært et ønske at det skulle komme muligheter til å flytte butikken ned på gateplan. Ønsket ble oppfylt da Kiwi bygde nye lokaler til sin butikk. Da ble det ledige lokaler på andre siden av parkeringsplassen mellom de to sentrene.
– Vi gleder oss veldig til å få alt på plass i de nye lokalene. Det blir enklere både for oss og kundene å få alt ned på gateplan, sier Siv Anita Grande.
Hun forteller om en svært hektisk periode hvor absolutt alle varene i andre etasje ble fraktet til nye lokaler.
– Vi har flyttet varer hver dag i to uker, sier Grande.
Nytt
Siv Anita Grande forteller at det nye butikklokalet de flytter til er omtrent like stort som det de flytter fra. Men både ansatte og kunder vil merke endringer.
– Vi får på plass et helt nytt konsept som vil gjøre butikken mer kundvennlig. Det vil bli mye enklere for kundene å finne fram til varer, sier Grande.
De ansatte i butikken har bidratt mye under flyttingen. I tillegg har butikken på Otta fått hjelp fra sentrale hold av kjeden for å legge best mulig til rette i de nye lokalene.
Jysk
Den 2. april åpnet verdens første Jysk Sengetøjslager i Danmark i Århus, hvor den fremdeles ligger. Siden den gang har kjeden åpnet butikker på løpende bånd både i Europa og andre steder i verden. Den 22. september åpnet Norsk Sengetøjslager sin første butikk i Norge. Den ble åpnet i Stavanger.
Austeja Ivanauskaite, Viktoria Kallåk Josten, Eskil Midtli og andre medarbeidere har hatt travle dager med å flytte varene i butikken. I dette bygget i Otta sentrum er det nye lokalet til butikken.





Godt utvalg innen rengjøring




Vi ønsker alle en god jul!



Ankarsrum Black kjøkkenmaskin





Adax panelovner
Nintendo Switch 2 spillkonsoll (Mario Kart World-pakke) Hollywood 9 LED sminkespeil




ELKJØP OTTA AS
Skansen 2A, Otta Tlf. 61 23 01 60 e-post:storemanager.otta@elkjop.no

Sulland Otta er autorisert merkeforhandler for Volkswagen, Ford og Mitsubishi. Vi tilbyr
Salg av nye og brukte biler
Merkeverksted
MECA-verksted
Bilskade og lakkverksted
Bilpleie
Dekkhotell




SULLAND OTTA Skansen 4 A Tlf: 61 23 62 60 sulland.no

Amaryllis Den skjønneste av de skjønne

Den er høyreist, elegant, sofistikert, overveldende. Nøysom også. Amaryllis hører jula til.
Olaug Furusæter er begeistret for denne løkplanten som mange kaller dronningen blant juleblomster.
Pryd
Dronning og kongelig er nettopp ord som også hun tar fram når hun beskriver amaryllis.
– Den er litt fornem og elegant, ja, litt kongelig eller majestetisk. Kjært barn, vet du! Det er umulig å overse den, høy stilk og store blomster i toppen som den har.

Tett i tett
Olaug driver Brua Blomsterverksted i Vålebru på fjerde året, en blomsterbutikk uten kjedetilknytning.
Før jul minner det intime butikklokalet om et overflødighetshorn.
Det er blomster og planter, lys og julestæsj over alt. I år har hun fått opp hyller helt opp til taket for å kunne vise fram alt av og smått som kan være med å gjøre hus og hytte julefine.

Hun har definitivt satt sitt preg på innredning og utvalg. Det er lite tradisjonelt julerødt her. Skal det først være rødt, foretrekker hun heller de mørkere nyansene.
Hennes palett består i hovedsak av varme jordfarger og de dusere alternativene på fargekartet.
Gull og bronse
Vakker og skjør juletrepynt og figurer til å henge opp i vindu glitrer i gull, sølv og bronse, tatt inn fra blant annet fra Belgia.

DET HVITE HUS: Brua Blomsterverksted nederst i Jernbanegata er vakkert julepyntet.
HELDEKK: Julefristelser fra gulv til tak.
Flere og flere har oppdaget amaryllis. Men noen har ennå til gode gleden ved å se den vokse og blomstre!
OLAUG FURUSÆTER
Brua Blomsterverksted, Vålebru
Tablåer av julepynt henger ned fra taket, de er mildt grønne, svalt ferskenfargede og kjølig blekblå. Grønne planter og blomstrende krukkevekster står tett i tett og minner om at vi er i et blomsterverksted. Midt i det hele et generøst pyntet juletre med spir i toppen.
Inngangspartiet er dekorert med lubne kranser bundet av gran, furu og einer og rundt vinduene henger vintergrønne ranker med lyslenker som dekor.
Lokalene er for øvrig nissefri sone.
– Nisser er å få kjøpt over alt. Jeg behøver ikke å ta opp konkurransen, sier hun nøkternt.
Vent på gleden
Så er det amaryllisen, da. I butikken står de skulder ved skulder og følger hverandres vekst. Noen er satt i skåler der den skyter til værs, med følge av mose og svibler rundt løken.
Hvordan få amaryllis til å slå ut i full blomst julaften?
– Nja, det er ikke så lett. Løken lever sitt eget liv, utstyrt med alt den trenger til å vokse. Jeg pleier å si at gled deg, bare gled deg til den slår ut i blomst, enten det skjer julaften eller i romjula eller i januar. Den er verdt å vente på, sier Olaug.
Selv om blomsterløken ikke kan omprogrammeres, kan den likevel påvirkes til en viss grad. Temperaturen er det viktigste styringsredskapet.
Ta tempen
Temperatur kan bremse eller akselerere vekst og blomstring. Synes du at løken vokser for raskt, så sett den kjølig for en periode. Vi du prøve å time den til den 24. kan det være smart å plassere den i et lyst vindu med rundt 20 grader.
Amaryllis trives godt i romtemperatur. Men snittblomsten vil leve lenger hvis den får stå litt kjøligere om natta.
Størrelse har betydning, stor og kraftig løk har mye næring til blomstring.

Råd og tips
Nettet er fullt av tips og råd om stell av amaryllis. Felles for dem er sparsom vanning og ingen gjødsling (løken har medbrakt matpakke til alle formål) Stilken vil strekke seg etter lyset, og det kan derfor være lurt å snu blomsterpotten jevnlig for å stimulere til rett og fin vekst.
Det kan også være fint å sette ned støtte til stilken, for den kan lett knekke når blomstringen er i gang.
Skal amaryllis brukes som snittblomster i vase, er det et tips å feste en tapebit nederst på stilken for å hindre at den krøller seg.
Bordpynt
– Vakrere bordpynt enn amaryllis finnes knapt, mener Olaug.
– Skjær av stilkene så den omfangsrike blomsten kan hvile på bordet/duken/annet underlag. Pynt gjerne med vintergrønt rundt blomstene, kanskje en lysslynge eller noe annet du liker. Men la amaryllisen spille hovedrollen.
Ellers kan man jo lage selv eller få blomsterhandleren til å lage en ranke av amaryllis. Det gjør susen på julaftensbordet!
TEKST OG FOTO: ANNE STOKKE
STELL: Amaryllis krever lite stell, men gir mye glede, forsikrer blomsterhandler Olaug Furusæter.
FÅVANG SKAFFERI ER EN DELIKATESSEBUTIKK PÅ FÅVANG
(Kvitfjelltunet), like ved E6 og avkjøring til Kvitfjell.
Hos oss nner du ekstra gode råvarer til deilige måltider som fersk sk, skikkelig mørt kjøtt og nydelige oster, ribbe av utegris, pinnekjøtt av fjellam og lute skloin av klipp sk.



La deg inspirere og få gode tips på instagram @favang ska eri Velkommen!
Stasjonsvegen 9, 2634 FÅVANG
Tlf. 948 79 292




Lokalbanken
fra
Gudbrandsdalen

har åpnet kontor i Oslo!
Et hjerte som banker for Gudbrandsdalen?
Nå er lokalbanken enda nærmere – enten du er hjemme i byen eller på hytta.

Den helt nye Subaru Solterra
Les mer og book møte pås1g.no/oslo


Subaru 50 år i Norge – og vi feirer med helt nye Solterra! Modellen leveres med permanent firehjulstrekk som standard, har inntil 520 km rekkevidde (WLTP)* og 1.500 kg tilhengerkapasitet. Nytt er også optimalisering av batteritemperatur via forvarming som gjør lading både raskere og mer effektivt, særlig under kalde forhold. En helelektrisk SUV som kombinerer Subarus legendariske pålitelighet med moderne elektrisk kraft.



JULEGAVETIPS
Morsomme krus fra Trend Design 129 kr
Varme tøfler fra Lexington 995 kr
Smykker fra Caroline Svedbom fra 399 kr
Håndsåpe fra Sprekenhus fra 310 kr
Lune fleecepledd fra Biederlack 1099 kr
Skjerf i kashmir fra Kvitfjell Handbags 499 kr
Myke håndklær fra Lexington fra 250 kr
Duftlys fra Voluspa fra 239 kr
Søte pledd til barn fra Biederlack 599 kr Fine drikkeflasker fra Swell 399 kr




























































































































































































































































































































Magny Grete Lien, Espen Solheim, Svein Tore Nymoen og Marianne Sletten
Otta



Styret i Otta handels- og næringsforening er klinkende klare i sin oppfordring til folk som skal handle til jul.
Styremedlemmene oppfordrer folk flest til å bruke lokalt næringsliv.
– Det blir ikke lokale arbeidsplasser og liv i lokale butikker om folk handler julegaver og andre varer i nettbutikker. Skal vi fortsatt ha butikker og næringsliv må vi handle lokalt, er meldingen fra styret.
Stuttreist
Handels- og næringsforeningen setter alle kluter til for å skape en så god førjulsstemning som mulig i Otta sentrum. Næringsforeningen legger til rette for at folk som kommer på besøk skal oppleve god førjulsstemning i sentrum. Samtidig håper styret i foreningen at den enkelte næringsdrivende også bidrar med å skape god førjulsstemning slik at folk som kommer til sentrum får gode opplevelser i førjulstiden.
– Vi har fått god hjelp fra Sel kommune i forbindelse med å skape førjulsstemning. Det er vi veldig glade for, er meldingen fra styret i Otta handels- og næringsforening.
Tradisjon
Førjulstiden er ofte forbundet med tradisjoner. Slik er det også på Otta. Handelsstanden åpner dørene to søndager i desember, og det blir
julemarked i kjøpesenteret Alti.
Så melder styret i handelsstanden at de har lagt til rette for et gratislotteri der alle som handler i lokale butikker er med i trakning av premier gitt av næringslivet. Skriv navn og telefonnummer på kvitteringen, legg den i en kasse som er beregnet til formålet og kundene er med i trekningen.
Populært
Otta handels- og næringsforening har også egne kort folk flest kan kjøpe for å bruke i flere av butikkene.
– Ottakortet er et populært tiltak. Mange kjøper dette og gir som gaver. Det er også mange lokale bedrifter som kjøper Ottakortet og gir som julegave til de ansatte. Dette har vist seg å være en populær julegave, sier Marianne Sletten i Otta handels- og næringsforening.
Styret i næringsforeningen peker på at folk som får Ottakortet i gave gjerne bruker disse i butikkene i januar og februar og gjennom det bidrar til omsetning i ellers så stille handelsmåneder, januar og februar.
– Skal vi fortsatt ha et levende lokalsamfunn, må vi også bruke det lokale næringslivet, sier Sletten.





Her har de små muligheter til å bli avbildet som snømann.
Det er montert mange objekter som skal lyse og skape førjulsstemning i Otta sentrum.

Et løft for Gålå inn i framtida
Denne vinteren markerer et viktig vendepunkt for Gålå. Med ny heis i Valsfjell, et stort lokalengasjement og over 300 deltakerne i Gålåløftet, går Gålå inn i sesongen med ny energi – og en stolt tradisjon i ryggen.
Gålå har vært et sted for rekreasjon, ro og fjellopplevelser siden slutten av 1800-tallet. Generasjoner har reist hit for å finne hvile, aktivitet og natur som rommer både stillhet og inspirasjon. Den første heisen i Blåbærfjell ble bygget på 1950-tallet. Stolheisen som nå er borte, ble bygget i 1987.
Denne vinteren skriver vi videre på historien.
En ny heis, og ny giv i Valsfjell Høsten har vært preget av arbeid, helikopterløft, montering og finjustering i Valsfjell. Den nye heisen markerer ikke bare et teknisk løft, men et tydelig signal om framtidstro.
Med gjenåpning av Valsfjell går Gålå Alpin og Aktiv fra å være én skiheis til å bli et mer moderne og tilgjengelig skisenter. Et skianlegg med mer kapasitet, bedre flyt og nye muligheter for hele området.
Gålåløftet: Lokal kraft i praksis
Da Gålåløftet ble lansert ved påsketider i år var det med en klar idé: At utviklingen av
Gålå skal skje sammen med dem som bruker fjellet, bor her, har hytter her eller i nærheten og er glad i destinasjonen.
Responsen har vært overveldende. Over 300 deltakere og flere lokale bedrifter har bidratt med økonomi, entusiasme og tillit, og gjort det mulig å realisere løftet. I tillegg har vi opplevd stor interesse og støtte fra lokalmiljøet, Peer Gynt Alpinklubb og Fron Thrasher Team. Det er stas med så mange som heier oss fram!
Sammen har vi løftet fram en satsing som er større enn heisen i seg selv. En satsning som handler om fellesskap, investering i framtida og om å styrke Gålå som helhetlig vinterdestinasjon.
En destinasjon for hele dalen
Gålå er i utvikling. Men samtidig forblir mye som det alltid har vært: Familievennlig terreng, uformell stemning, romslig natur og en personlig og varm tilstedeværelse som gjør at mange finner «vinterhjemmet» sitt her.
Satsingen i Valsfjell og engasjementet fra lokalmiljøet gir et solid fundament for å utvikle Gålå videre, til glede for hytteeiere, fastboende og alle som søker gode vinterdager til fjells.

Velkommen til sesongåpning 20. og 21. desember!
Vi gleder oss til å åpne anlegget og dele resultatet av arbeidet med dere. Følg oss i sosiale medier og på nettsiden vår for å få med deg informasjon om sesongåpningen. Skianlegget vil være åpent hver dag fra 20. desember, sjekk nettsiden for åpningstider.
Nå er vi klare for nye svinger, nye møter og nye historier, på en fjelldestinasjon som både bærer tradisjon og bygger framtid.